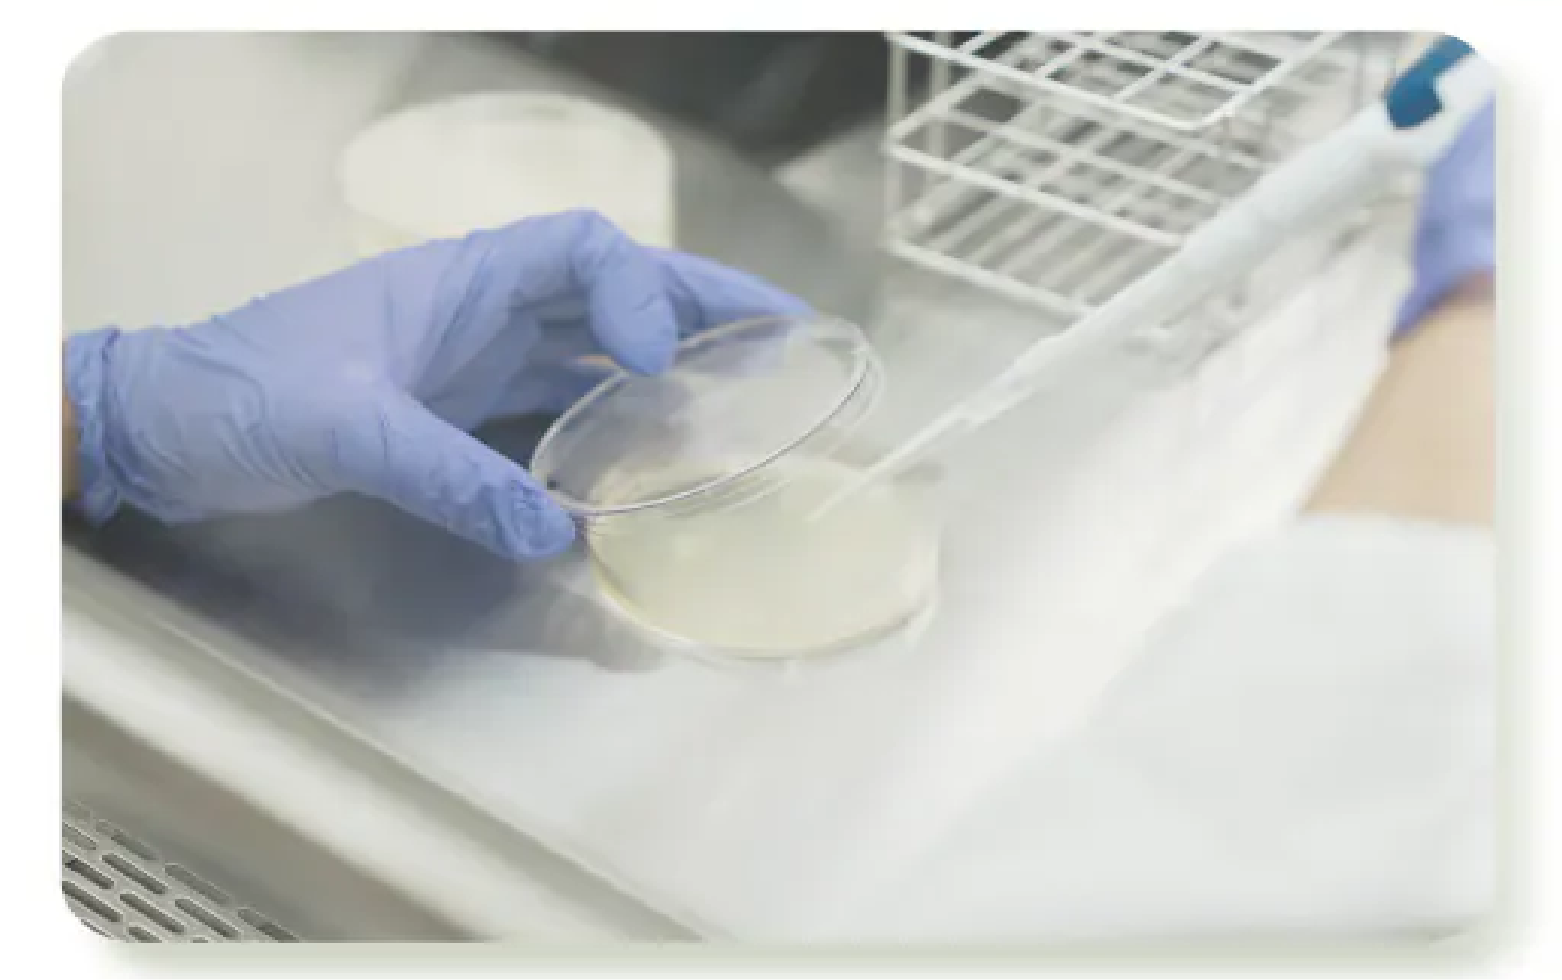
艸研所 ISO 22716 實驗室

QUALITY ASSURANCE / VOL. 03
研發的深度,定義純淨的高度:
每一滴皂液的卓越革命
艸研所深耕於液態皂工藝,擁有自主 ISO 22716 國際認證實驗室。
我們不只是製造者,更是純淨洗沐標準的守護者。
為什麼漲價一倍,我們依然堅持選用這支橄欖油?

— 義大利 Olitalia 冷壓初榨橄欖油:純淨度與穩定性的最高標準 —
在研發初期,我們嘗試過數十種冷壓初榨橄欖油,卻面臨了殘酷的現實:多數油品在皂化後穩定性不足。在無數次的失敗中,唯有義大利 奧利塔Olitalia 的油品,能通過我們實驗室最嚴苛的測試。
「全球僅三間橄欖油廠擁有的技術」
根據原廠資料,目前全球僅有三間橄欖油供應商擁有在冷壓不加熱的情況下去除雜質的專利技術設備。這正是確保皂液能經歷 45 天靜置熟成卻依然純淨的核心祕密。
洗劑界的巔峰:AA 100% 無添加
| 認證等級 | 無添加要求 | 技術難度 |
|---|---|---|
| 一星 / 二星 | 排除部分成分 | ★☆☆☆ |
| 三星認證 | 排除大多數添加 | ★★★☆ |
| 100% 無添加 | 0% 化學添加 | ★★★★ |
製造實力與研發優勢
— 艸研所自主 ISO 22716 國際認證實驗室 —
廠內配備專業耐受性試驗設備,確保皂液在不同氣候下,皆能維持最優異的穩定品質。
ISO 22716 規範下生產,完整保留油脂中的營養成分,這是大化工廠難以企及的精細度。
堅持 1,000 小時以上的靜置熟成,等待 pH 值自然達到親膚平衡,賦予皂液細緻靈魂。
從自有品牌到專業研發
這種對細節毫不妥協的研發靈魂,不僅是我們守護家庭的初心,
更是我們與專業合作夥伴共同定義洗沐標準的實力證明。